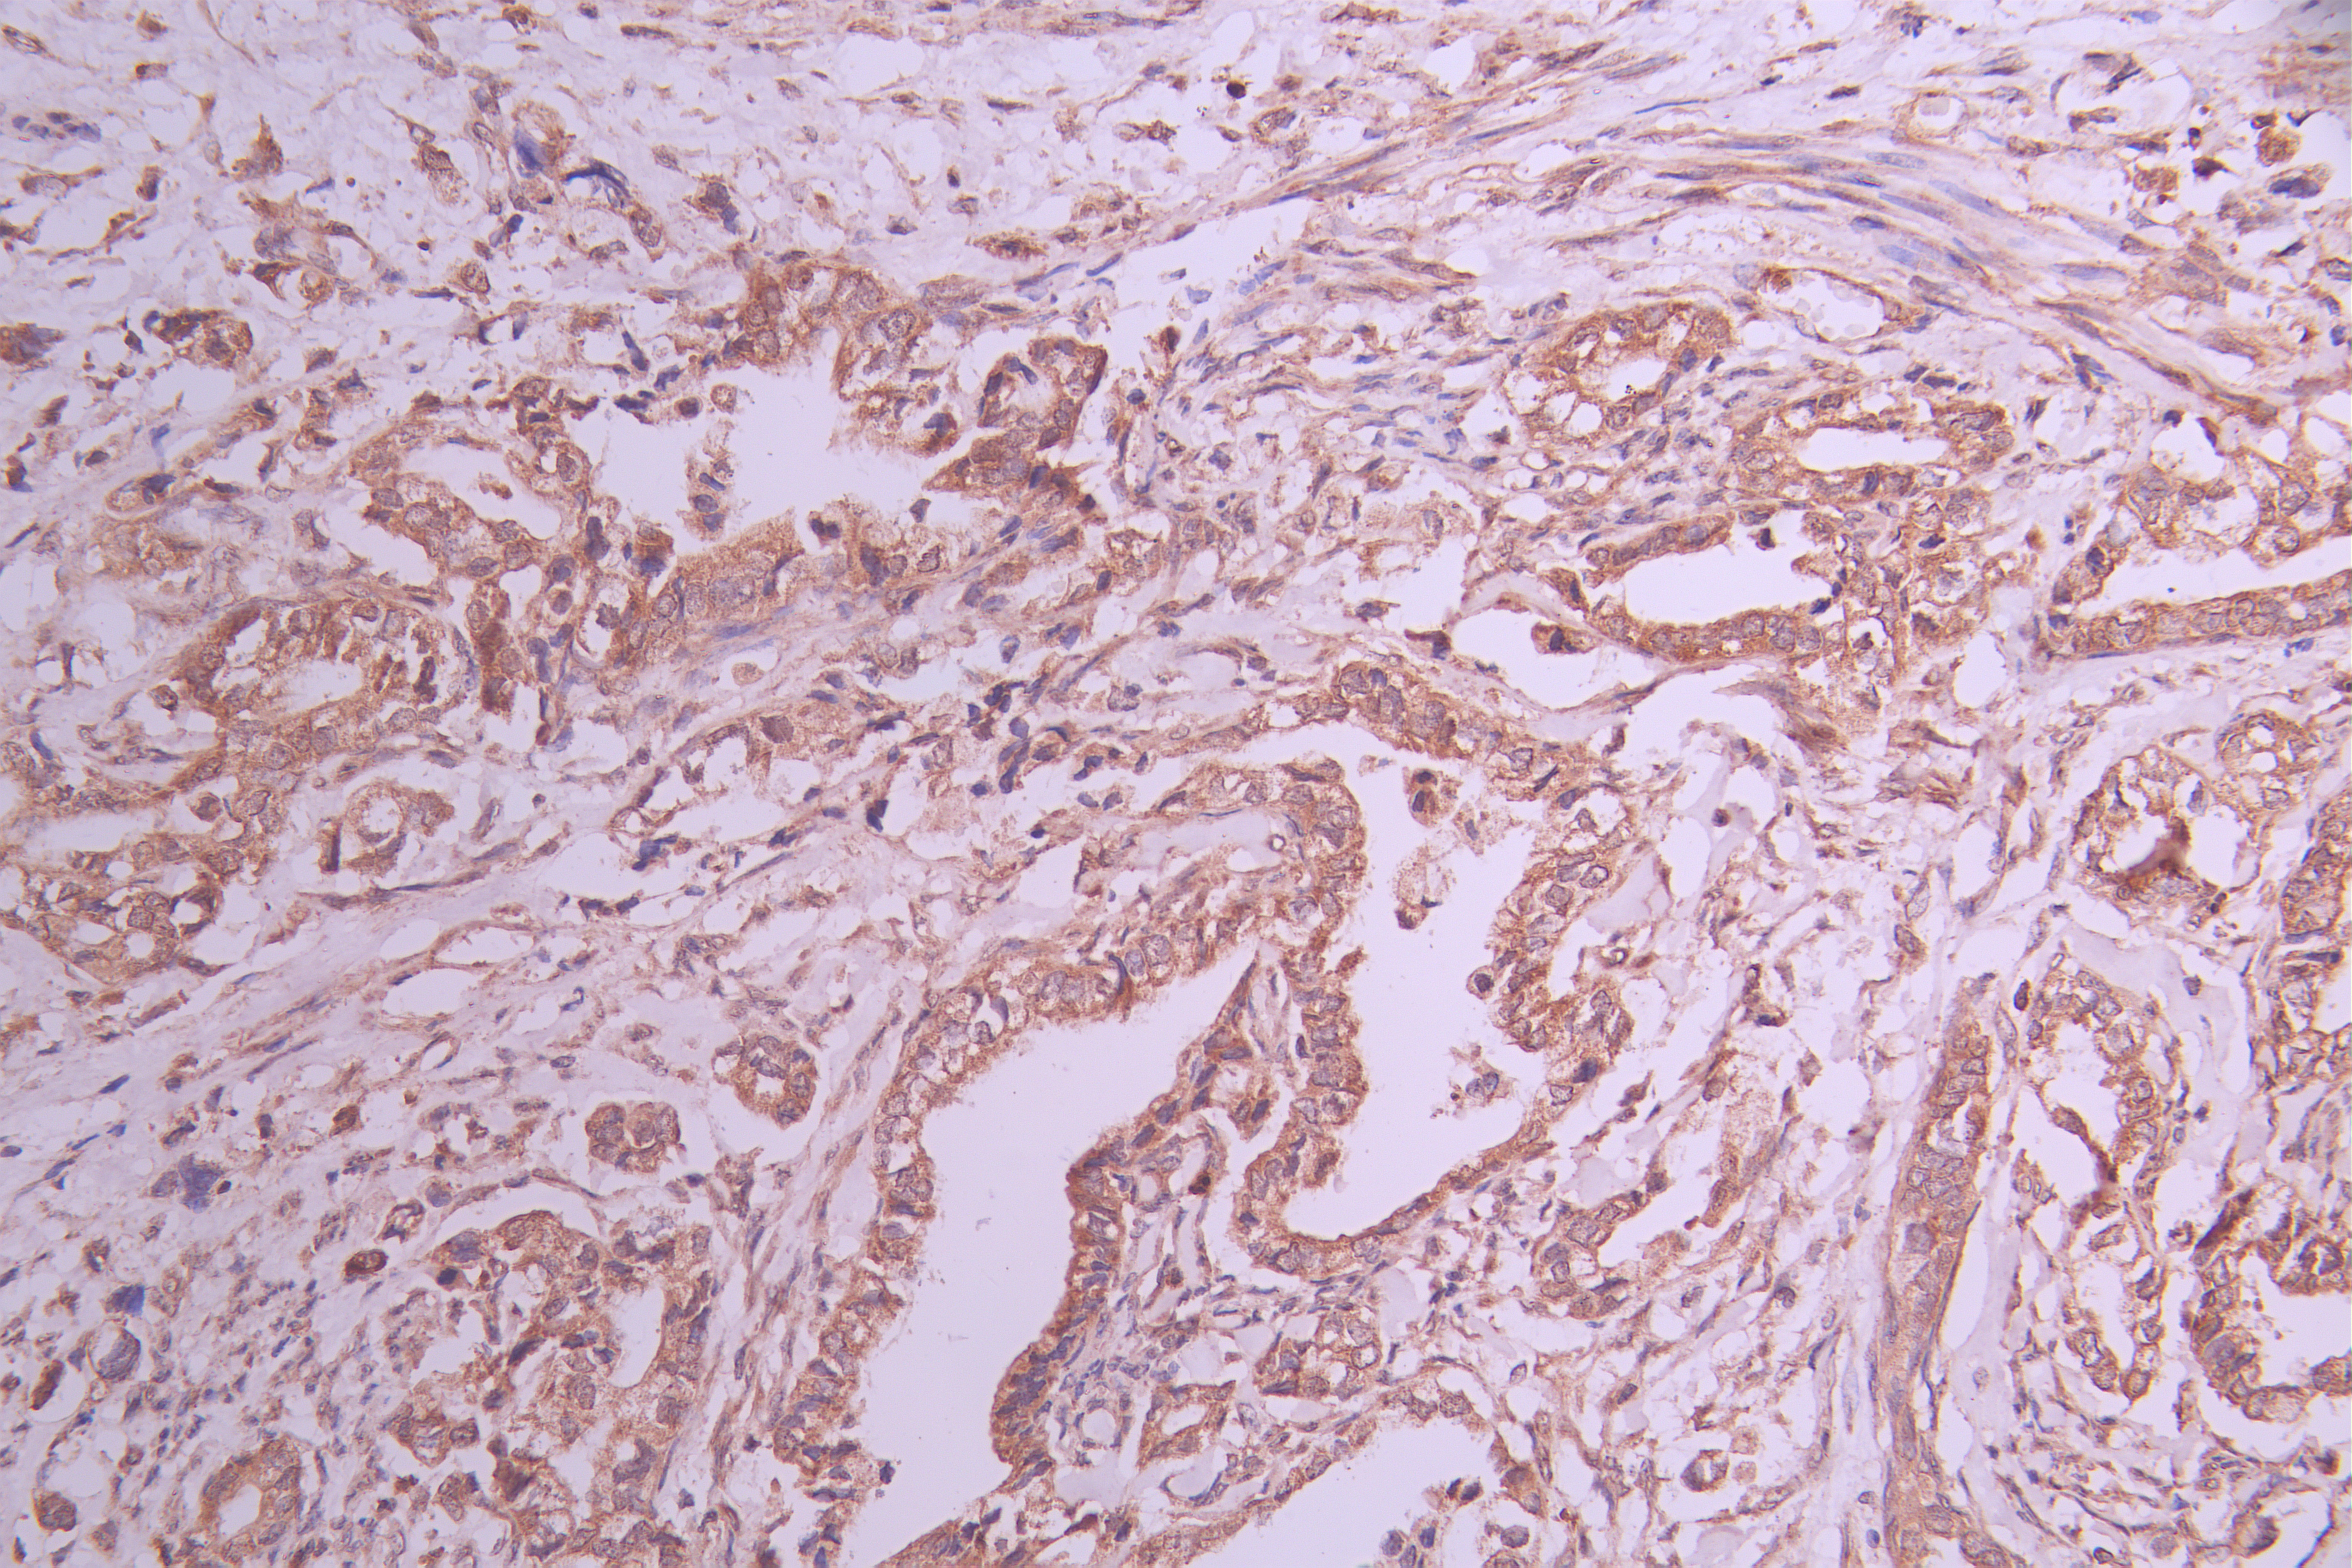

EHD1 Recombinant Monoclonal Antibody
-
中文名稱:EHD1 Recombinant Monoclonal Antibody
-
貨號:CSB-RA547153A0HU
-
規格:¥1320
-
圖片:
-
Western Blot
Positive WB detected in: SW620 whole cell lysate(30μg), A-431 whole cell lysate(30μg), A549 whole cell lysate(30μg), HeLa whole cell lysate, NIH/3T3 whole cell lysate(30μg), Mouse brain tissue lysate(30μg)
All lanes: EHD1 antibody at 1:1000
Secondary
Goat polyclonal to rabbit IgG at 1/50000 dilution
Predicted band size: 61 kDa
Observed band size: 61 kDa
Exposure time: 3min -
IHC image of CSB-RA547153A0HU diluted at 1:100 and staining in paraffin-embedded human cervical cancer performed on a Leica BondTM system. After dewaxing and hydration, antigen retrieval was mediated by high pressure in a citrate buffer (pH 6.0). Section was blocked with 10% normal goat serum 30min at RT. Then primary antibody (1% BSA) was incubated at 4°C overnight. The primary is detected by a Goat anti-rabbit polymer IgG labeled by HRP and visualized using 0.05% DAB.
-
Overlay Peak curve showing PC-3 cells stained with CSB-RA547153A0HU (red line) at 1:100. The cells were fixed in 4% formaldehyde and permeated by 0.2% TritonX-100 for 10min. Then 10% normal goat serum to block non-specific protein-protein interactions followed by the antibody (1ug/1*106cells) for 45min at 4℃. The secondary antibody used was FITC-conjugated goat anti-rabbit IgG (H+L) at 1/200 dilution for 35min at 4℃.Control antibody (green line) was Rabbit IgG (1ug/1*106cells) used under the same conditions. Acquisition of >10,000 events was performed.
-
-
其他:
產品詳情
-
Uniprot No.:
-
基因名:
-
別名:CDABP0131 antibody; EH domain containing 1 antibody; EH domain-containing protein 1 antibody; EHD1 antibody; EHD1_HUMAN antibody; FLJ42622 antibody; FLJ44618 antibody; H PAST antibody; hPAST1 antibody; PAST antibody; PAST homolog 1 antibody; PAST1 antibody; Testilin antibody
-
反應種屬:Human, Mouse
-
免疫原:A synthesized peptide derived from human EHD1
-
免疫原種屬:Homo sapiens (Human)
-
標記方式:Non-conjugated
-
克隆類型:Monoclonal
-
抗體亞型:Rabbit IgG
-
純化方式:Affinity-chromatography
-
克隆號:13D3
-
濃度:It differs from different batches. Please contact us to confirm it.
-
保存緩沖液:Rabbit IgG in 10mM phosphate buffered saline , pH 7.4, 150mM sodium chloride, 0.05% BSA, 0.02% sodium azide and 50% glycerol.
-
產品提供形式:Liquid
-
應用范圍:ELISA, WB, IHC, FC
-
推薦稀釋比:
Application Recommended Dilution WB 1:500-1:2000 IHC 1:50-1:200 FC 1:50-1:200 -
Protocols:
-
儲存條件:Upon receipt, store at -20°C or -80°C. Avoid repeated freeze.
-
貨期:Basically, we can dispatch the products out in 1-3 working days after receiving your orders. Delivery time maybe differs from different purchasing way or location, please kindly consult your local distributors for specific delivery time.
-
用途:For Research Use Only. Not for use in diagnostic or therapeutic procedures.
相關產品
靶點詳情
-
功能:ATP- and membrane-binding protein that controls membrane reorganization/tubulation upon ATP hydrolysis. In vitro causes vesiculation of endocytic membranes. Acts in early endocytic membrane fusion and membrane trafficking of recycling endosomes. Recruited to endosomal membranes upon nerve growth factor stimulation, indirectly regulates neurite outgrowth. Plays a role in myoblast fusion. Involved in the unidirectional retrograde dendritic transport of endocytosed BACE1 and in efficient sorting of BACE1 to axons implicating a function in neuronal APP processing. Plays a role in the formation of the ciliary vesicle (CV), an early step in cilium biogenesis. Proposed to be required for the fusion of distal appendage vesicles (DAVs) to form the CV by recruiting SNARE complex component SNAP29. Is required for recruitment of transition zone proteins CEP290, RPGRIP1L, TMEM67 and B9D2, and of IFT20 following DAV reorganization before Rab8-dependent ciliary membrane extension. Required for the loss of CCP110 form the mother centriole essential for the maturation of the basal body during ciliogenesis.
-
基因功能參考文獻:
- Results suggest that EHD1 is a cisplatin (CDDP)-resistant gene that suppresses DNA adduct-induced apoptosis by modulating intracellular CDDP concentrations. PMID: 27411790
- this study shows that overexpression of EHD1 induced the epithelial-mesenchymal transition and increased the metastatic potential of lung cancer cells in vitro and in vivo PMID: 27531895
- RAB11FIP3 combines with Eps15 homology domain 1 to promote the endocytosis recycling of phosphorylation of epithelial growth factor receptor. PMID: 28215104
- van der Waals interactions should be the main consideration when we design peptide inhibitors of EHD1 EH domain with high affinities. PMID: 26465136
- Authors found that Eps15-homology domain 1 (EHD1), a protein that associates with the endocytic recycling compartment (ERC), colocalizes with active R-Ras in transiently expressed HeLa cells. PMID: 26378252
- that Molecule Interacting with CasL Like-1 and Eps15 Homology Domain protein 1 differentially influence microtubule dynamics during early and late mitosis PMID: 25287187
- Transport through recycling endosomes requires EHD1 recruitment by a phosphatidylserine translocase. PMID: 25595798
- Data indicate that concordant transforming growth factor-beta1 (TGFbeta-1) positive and EH-domain containing 1 (EHD1) negative as a strong favorable prognosis factor in non-small cell lung cancer (NSCLC). PMID: 24946721
- MICAL-L1-mediated recruitment of EHD1 to Src-containing recycling endosomes is required for the release of Src from the perinuclear endocytic recycling compartment in response to growth factor stimulation. PMID: 24481818
- evidence that the functions of both EHD1 and EHD4 are primarily in TRE membrane vesiculation, whereas EHD3 is a membrane-tubulating protein. PMID: 24019528
- the lipid modifier cPLA2alpha and EHD1 are involved in the vesiculation of CD59-containing endosomes PMID: 22456504
- Rabankyrin-5 interacts with EHD1 and Vps26 to regulate endocytic trafficking and retromer function PMID: 22284051
- EHD1 is involved in the control of CD59 transport from pre-sorting endosomes to the ERC in a PKC-dependent manner PMID: 20961375
- A new class of cardiac trafficking proteins(EHD1, EHD2, EHD3, EHD4) regulates cardiac membrane protein targeting. PMID: 20489164
- The results indicate that NPF is the preferred binding motif for the EHD1 EH-domain, but both the DPF and GPF motifs are capable of binding with lower affinity. PMID: 19798736
- These data implicate MICAL-L1 as an unusual type of Rab effector that regulates endocytic recycling by recruiting and linking EHD1 and Rab8a on membrane tubules. PMID: 19864458
- A tubular EHD1-containing compartment involved in the recycling of major histocompatibility complex class I molecules to the plasma membrane PMID: 12032069
- EHD3: a protein that resides in recycling tubular and vesicular membrane structures and interacts with EHD1. PMID: 12121420
- a novel interacting partner for EHD1, rabenosyn-5, was revealed. PMID: 15020713
- ATP binding is required for oligomerization of mRme-1/EHD1, which in turn is required for its association with endosomes PMID: 15710626
- Data support a role for EHD1 in beta1 integrin recycling, and demonstrate a requirement for EHD1 in integrin-mediated downstream functions. PMID: 17284518
- Rab8a and Myosin Vb colocalize to a tubular network containing EHD1 and EHD3, which does not contain Rab11a. PMID: 17507647
- Solution structure of the 133 C-terminal residues of EHD1, which includes the EH domain, was solved. PMID: 17899392
- Results show that EHD1 undergoes serine-phosphorylation, and suggest that EHD1 phosphorylation occurs between early endosomes and the endocytic recycling compartment. PMID: 18661112
- Data show that EH domain mutant (K483E) that associates exclusively with punctate membranes displayed decreased binding to phosphatidylinositol-4-phosphate and other phosphoinositides. PMID: 19369419
顯示更多
收起更多
-
亞細胞定位:Recycling endosome membrane; Peripheral membrane protein; Cytoplasmic side. Early endosome membrane; Peripheral membrane protein; Cytoplasmic side. Cell membrane; Peripheral membrane protein; Cytoplasmic side. Cell projection, cilium membrane; Peripheral membrane protein; Cytoplasmic side.
-
蛋白家族:TRAFAC class dynamin-like GTPase superfamily, Dynamin/Fzo/YdjA family, EHD subfamily
-
組織特異性:Highly expressed in testis.
-
數據庫鏈接:
Most popular with customers
-
-
YWHAB Recombinant Monoclonal Antibody
Applications: ELISA, WB, IHC, IF, FC
Species Reactivity: Human, Mouse, Rat
-
Phospho-YAP1 (S127) Recombinant Monoclonal Antibody
Applications: ELISA, WB, IHC
Species Reactivity: Human
-
-
-
-
-